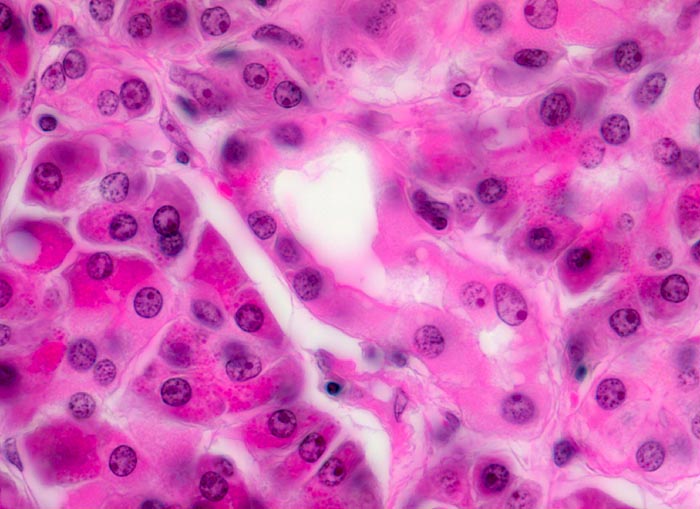

PathoPic – image database / PathoPic ID 4350 - Normales exokrines Pankreas
de
Diagnose
Normales exokrines Pankreas
Diagnose Gruppe
Normalbefund
Topographie
Pankreas
Topographie Gruppe
Leber, Gallenwege, Pankreas
Beschreibung
Links und rechts im Bild Azini des exokrinen Pankreas gruppiert um ein Schaltstück mit hellem kubischem Epithel in der Bildmitte.
Bilder Typ
Histologie
Alter
81
Geschlecht
männlich
Datum
Ersteintrag: 05.04.2002